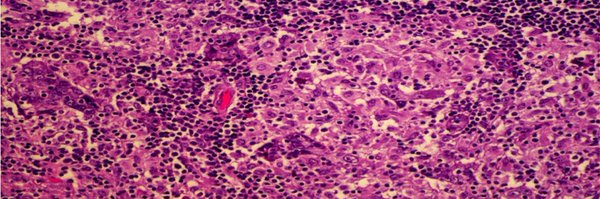
TILsWorkGroup Profile Banner

TILs Working Group
@TILsWorkGroup
Followers
838
Following
153
Media
40
Statuses
254
We are interested in the immune infiltrate in Breast cancer and what it means for treatment and prevention.
All over the world
Joined December 2017
We've recently launched a global survey on the potential use of #TILs for future trial designs and use in daily practice. We would love to hear what you have to say 👇 https://t.co/RaEvMXuSYb
2
4
10
Such a privilege to be part of the international TIL Working Group @TILsWorkGroup and to collaborate with Dr. Salgado on NeoTIL. #SABCS @muschollings @stolaney1 @OncBrothers @LoiSher
0
2
9
0
7
18
Thank you to the International Working Group on #TILs in #breastcancer and all collaborators for their work in the #APHINITY #TILs exploratory analysis and in advancing #breastcancerresearch. Listen to an important message from Dr. Roberto Salgado as #SABCS25 draws to a close.
0
7
13
Amazing presentation by Roberto Salgado from @TILsWorkGroup TIL assessment of APHINITY using CASE45 AI model and manual TILs (great ICC) Combining AI and manual assessment is a better prognostic biomarker than either one of them
0
4
4
TILs matter in HER2+ BC! In ShortHER trial, mapping their spatial organization with AI assessing: 🔹Immune-tumor interaction 🔹Aggregates/TLS (Hotspots) further refines prognosis beyond manual evaluation PS2-08-11 at #Sabcs25 @UniPadova @iov_irccs @TILsWorkGroup
0
4
5
Tagging @TILsWorkGroup to amplify this great work
✨✨hot off the press from the #loilab. We show here that pregnancy & breastfeeding is associated with increased T cells in the normal breast and protection against #tnbc #breastcancer moving the role of immunity from treatment to prevention. 👏👏Thanks to @FAndreMD @DrChoueiri
0
1
3
✨✨hot off the press from the #loilab. We show here that pregnancy & breastfeeding is associated with increased T cells in the normal breast and protection against #tnbc #breastcancer moving the role of immunity from treatment to prevention. 👏👏Thanks to @FAndreMD @DrChoueiri
Translational data shows that #breastfeeding helps personal immunity improving CD8+ T This work can help to understand better the immune system and breastfeeding mechanisms @LoiSher @OncoAlert #ESMO25 @FernandoOnco
5
34
94
The EU-funded MSCA Doctoral Network “Spatial Crosstalk in Immune-Oncology” (SpaXio) is now officially recruiting 14 PhD students to decipher the metastasis-promoting microenvironment of colon and breast cancer. More info here:
0
1
0
😎if #TIL had been the prespecified biomarker, pembrolizumab might well be approved for this indication. PD-L1 IHC has real technical limitations- patients deserve multiple validated ways to identified immune enriched tumors. #TILs are simple, free & readily available- wait 🤔is
💫🌟Association of potential biomarkers with clinical outcomes in metastatic TNBC treated with pembrolizumab or chemotherapy 👉 https://t.co/NomK14VXl4
@JavierCortesMD @ProfAnthoG @ASCOPres @Prof_Nadia_H @LoiSher 🧬 KEYNOTE-119 exploratory biomarker analysis 🔹 TILs ≥5% → ↑
1
18
55
Study across 45 institutions shows AI validity in TIL quantification for melanoma. Reproducible with prognostic validity and open-source. @tznaung 👉 https://t.co/CprLGJYH80
#AIinPathology #Melanoma #ComputationalPathology
jamanetwork.com
This prognostic study compares the analytical and clinical validity of a machine learning algorithm with traditional pathologist-read methods for quantification of tumor-infiltrating lymphocytes in...
0
0
2
Some studies shows how we can reduce costs based on biomarkers SHORT-HER 9 weeks of trastuzumab is ✅ based TILS 20% or more @TILsWorkGroup @OncoAlert #oncoalertAF @JAMAOnc⤵️
jamanetwork.com
This 10-year follow-up analysis of the ShortHER randomized clinical trial evaluates the association of tumor-infiltrating lymphocytes with distant disease-free and overall survival among patients...
1
11
24
📄 Pitfalls in ML-based TIL assessment 🔗 https://t.co/qpf9qZ1zbt 📄 Spatial analyses of immune infiltration in cancer 🔗 https://t.co/8HlHlVhla9
#ImmunoOncology #DigitalPathology #TILs
pathsocjournals.onlinelibrary.wiley.com
Modern histologic imaging platforms coupled with machine learning methods have provided new opportunities to map the spatial distribution of immune cells in the tumor microenvironment. However,...
0
0
0
🎉 Thrilled to share that 2 @JPathol papers from the TILs Working Group ranked in the Top 10% most-viewed in 2023! 👏 Huge thanks to all collaborators, @JPathol & our readers for your support. 📎 Links in comments ⬇️ #TopViewedArticle #TILsinBreastCancer #pathology
1
0
0
Great slide highlighting not only are TILs predictive of pCR...it also translates to being prognostic beyond pCR for good outcome and DFS. Seems like we have a LOT of data on TILs now, why aren't they standardly provided on path reports???🧐 #SABCS24
@SABCSSanAntonio
@OncoAlert
2
11
37
🤩🍾10th anniversary TILs-Working Group at @SABCSSanAntonio 2024 - everyone welcome! RSVP here: https://t.co/xMkVqwGYr7
0
0
0
The largest TILs-Workshop done so far! More than 100 pathologist, residents in training and medical students learning how to score TILs. Organized by the Narayana Medical College, India. Who follows? 💪🏼
0
2
15
Join us for the 2024 Peter Mac Breast Cancer Medical Oncology Education Day! 📅 On Friday, 11th October, dive into the latest in breast cancer care with experts at Peter Mac or via Zoom. Registrations: https://t.co/3OihTUlqSt
@PeterMacRes @PeterMacCC
1
1
0